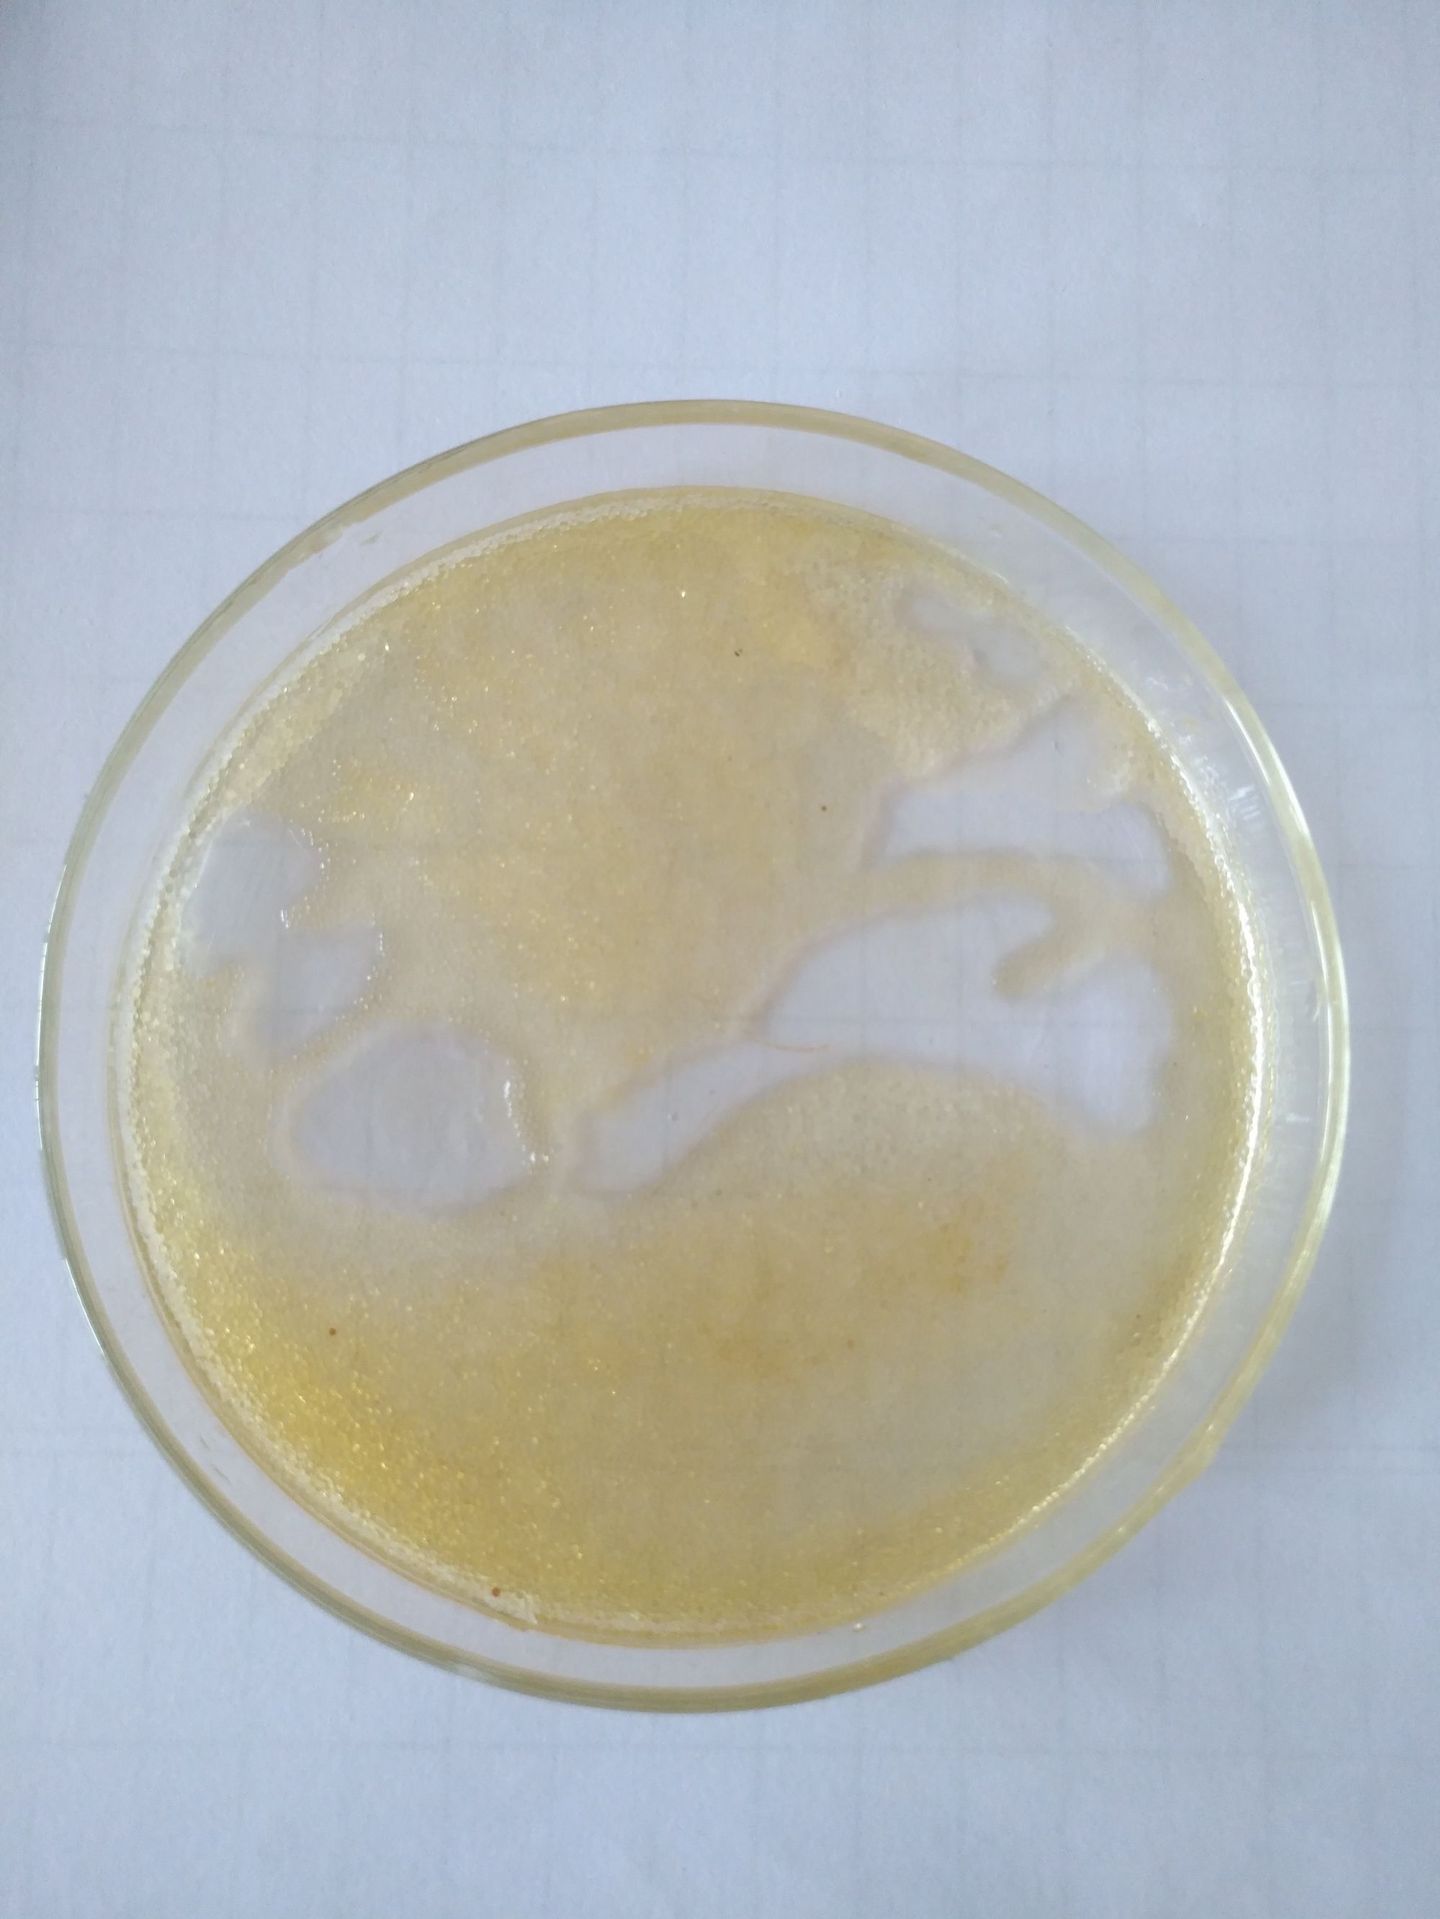
001x7w阳离子交换树 无二氯乙烷 直接磺化纯水高纯度

1688工业品为您提供在线免费查询更多合成树脂详细参数、实时报价、规格一览表。更多关于合成树脂多少钱一千克/合成树脂报价明细/合成树脂规格型号价格表/合成树脂批发市场价格/合成树脂官方报价等咨询,尽在1688工业品。询底价>
为你找到离子交换树脂相关产品

批发销售 大孔型强酸性苯乙烯系阳离子交换树脂 让利销售
天津
在线询价
001x7w阳离子交换树 无二氯乙烷 直接磺化纯水高纯度
江苏镇江
在线询价

福建离子交换树脂 除镍树脂 离子交换树脂厂家
天津
在线询价

阳离子交换树脂|001*7|软化水处理|树脂|732等型号耐腐耐腐蚀
福建莆田
在线询价

S112 大孔型强酸性阳离子交换树脂 色可赛思牌
江苏常州
在线询价

厂家直销 漂莱特Purolite® C115 离子交换树脂
山东济宁
在线询价

离子交换法用于冶炼提纯、铼分离提取、色可赛思树脂吸分离提取铼
江苏常州
在线询价

锅炉软化水处理树脂 钠型工业级树阳离子交换树脂颗粒D001
上海
在线询价

海南离子交换树脂 除磷树脂厂家 欢迎致电购买
天津
在线询价

【耀阳牌】国标电标阴阳离子交换树脂 质量 001X7钠型树脂
天津
在线询价

C107E大孔弱酸性丙烯酸离子交换树脂 色可赛思牌
江苏常州
在线询价

耀阳牌离子交换树脂厂家 污水处理树脂 阳离子交换树脂厂家
天津
在线询价
查看更多产品及报价
100+离子交换树脂相关产品等你解锁
在线寻源3000行家正在找货
免费询价,源头正品,上1688工业品,全国的工业正品交易平台





